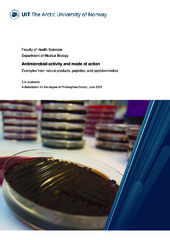

Doktorgradsavhandlinger (Helsefak): Nye registreringer
Viser treff 161-180 av 770
-
The Regulation of Steroid Receptor Co-activator-3 Activity by p38MAPK-MK2 Signaling Pathway
(Doctoral thesis; Doktorgradsavhandling, 2022-10-14)Steroid receptor co-activator-3 (SRC-3) is a co-activator that plays important roles in normal physiology and different diseases including cancer. Its activity is regulated by phosphorylation. Serine 857 (S857) is the most frequently reported phosphorylation site of SRC-3. In this work, we examined several kinases that could phosphorylate SRC-3 at S857 and explored the functional outcome incurred ... -
Epithelial ovarian cancer. Population-based cohort studies. The NOWAC Study and Postgenome biobank
(Doctoral thesis; Doktorgradsavhandling, 2022-10-19)Important gaps in population-based epidemiological research on ovarian cancer include understanding how risk factors relate to cancer subtypes and anatomical sites, identifying safe and effective preventive measures, and getting a more detailed picture of the continuum of events during ovarian carcinogenesis. This thesis used prospective exposure information from the Norwegian Women and Cancer (NOWAC) ... -
Interpersonal competence in challenging encounters: Towards a paradigm shift in human services - Creating conditions for professional development through action research and trauma-informed restorative practice
(Doctoral thesis; Doktorgradsavhandling, 2022-10-04)Helse- og sosialarbeidere, i private og offentlige arbeids- og velferdstjenester, har daglig kontakt med mennesker som har traumeerfaringer og sammensatte behov. Kommunikasjonen kan være følelsesmessig utfordrende og mange fagpersoner opplever dårlig tid, utrygghet og stress i arbeidet. Utrygghet og stress øker konfliktnivået og har en negativ effekt på fagpersoners velvære, holdninger til tjenestebrukere ... -
Clinical characteristics, mortality and pain tolerance in stable versus acute presentation of coronary heart disease
(Doctoral thesis; Doktorgradsavhandling, 2022-09-30)<p>Despite immense progress in the prevention, diagnosis and treatment of coronary heart disease, several challenges remain. In more than half of patients referred to coronary angiography for stable and unstable angina, no obstructive coronary artery disease (CAD) is found. At the same time, some patients present for the first time with already extensive CAD. Further, the management of unstable ... -
Prevalence, vascular complications, and level of health care treatment in individuals with type 2 and type 1 diabetes mellitus
(Doctoral thesis; Doktorgradsavhandling, 2022-10-04)The total prevalence of diabetes and vascular complications is increasing. Consequently, it is important to provide diabetes treatment according to the National clinical guideline for the management of diabetes and allocate individuals to the right level of health care in line with the National guideline for prioritization in specialist health care – Endocrinology and endocrine surgery. We used data ... -
Interleukin 33: a locally induced alarmin in the colonic mucosa of ulcerative colitis
(Doctoral thesis; Doktorgradsavhandling, 2022-09-27)Ulcerative colitis (UC) is a chronic inflammatory bowel disease involving the mucosal lining of the large bowel (colon and rectum). Common symptoms include bouts of diarrhoea, rectal bleeding and abdominal pain. The pathogenesis of UC is complex and multifactorial. This thesis investigated interleukin 33 (IL-33), an alarmin of the innate immune system. IL-33 is of interest as it is found to be ... -
Oral health in pregnancy: changes in oral bacterial milieu related to cariogenic bacterial load, oxidative stress and nitric oxide levels in the saliva and their effect on pregnancy outcome
(Doctoral thesis; Doktorgradsavhandling, 2022-09-16)The physiological changes that occur during the pregnancy are known to affect women´s oral health. Pregnant women are more vulnerable to oral diseases when compared to non-pregnant. Better understanding of the relation between changing oral microbial milieu and risk of pregnancy complications and associated mechanisms could help to improve maternal and perinatal outcomes. Thus, we aimed to investigate ... -
Childhood Trauma in Schizophrenia Spectrum Disorders: A comparison to substance abuse disorders, and relation to cognitive performance and antipsychotic treatment outcomes
(Doctoral thesis; Doktorgradsavhandling, 2022-09-15)An increasing body of research points to the importance of childhood trauma (CT) in psychosis, and as a risk factor for schizophrenia spectrum disorders (SSDs). The aim of this thesis was to investigate and compare the frequency and severity of CT in relation to clinical aspects and treatment outcomes in SSDs. The Childhood Trauma Questionnaire Short-Form (CTQ-SF) was used to retrospectively measure ... -
The role of interleukin-1 receptor antagonist in normal and malignant hematopoiesis
(Doctoral thesis; Doktorgradsavhandling, 2022-09-08)Interleukin-1β (IL-1β) is a pleiotropic inflammatory cytokine that exerts multiple roles in both physiological and pathological conditions. Enhanced IL-1β signaling drives hematopoietic stem cell (HSC) differentiation into the myeloid lineage and is actively involved in the development and progression of hematological malignancies, including deadly acute myeloid leukemia (AML). Inhibition of IL-1β ... -
Guanylate cyclase activators and stimulators. Potential cardiovascular therapeutics, with special focus on the right ventricle
(Doctoral thesis; Doktorgradsavhandling, 2022-09-09)<p><i>Background -</i> Soluble guanylate cyclase, sGC, is a major contributor to the signal transduction in the cardiovascular system, and dysfunction in the NO-sGC-cGMP signaling plays an important role in cardiovascular disease. This system is sensitive to a wide variety of pathological conditions spanning from substrate shortage to sGC-insensitivity to nitric oxide (NO), during pathological ... -
Optimizing medication therapy in older hospitalized patients. Identifying potentially inappropriate medications and testing an interdisciplinary intervention
(Doctoral thesis; Doktorgradsavhandling, 2022-08-26)The overall aim of this thesis is to provide knowledge on potentially inappropriate medications (PIMs) in hospitalized older patients and to investigate how clinical pharmacist services in an interdisciplinary setting can contribute to medication optimization and improve patient outcomes. First, we used national health registers to investigate how admissions to Norwegian geriatric hospital wards ... -
Novel screening methods for nanoscale changes in liver cell fenestrations elicited by pharmaceuticals
(Doctoral thesis; Doktorgradsavhandling, 2022-08-19)This thesis focuses on liver sinusoidal endothelial cells (LSEC) and one of their characteristic features called fenestrations. LSEC line the hepatic sinusoids and filter solutes from the plasma. The bidirectional transport of solutes between the bloodstream and the interior of the liver is facilitated via transcellular nanopores called fenestrations. Fenestrations are dynamic structures with diameters ... -
Venous Air Embolism and Complement-driven Thromboinflammation. In vitro human whole blood studies and in vivo porcine studies on the effect of air emboli on the complement system, cytokine network, and the hemostasis
(Doctoral thesis; Doktorgradsavhandling, 2022-09-27)<p><i>Background:</i> Air embolism may complicate many medical procedures and cause vascular occlusion, organ infarctions, or death. In vitro, air triggers the alternative complement pathway and activates platelets. Previous studies of air emboli were conducted in serum, plasma, or heparin anticoagulated whole blood, with ambient air present in tubes, precluding detailed examination of thromboinflammation. ... -
Antimicrobial activity and mode of action - Examples from natural products, peptides, and peptidomimetics
(Doctoral thesis; Doktorgradsavhandling, 2022-08-12)Infections caused by bacteria are the third leading cause of death worldwide. Antimicrobials are used to treat and prevent those infections and enabled the development of the modern healthcare system as we know it. However, those achievements are threatened by the global emergence of antimicrobial-resistant bacteria. There is an obvious need for developing new antimicrobials. Natural environments, ... -
Myocardial metabolic, structural and functional remodelling following nutritional and hormonal stress
(Doctoral thesis; Doktorgradsavhandling, 2022-06-22)The overall aim of this thesis was to increase our knowledge related to the underlying mechanisms of diabetes-induced cardiomyopathy. The primary objective of the first two papers was to elucidate the role of the reactive oxygen species (ROS) producing enzyme, NADPH oxidase 2 (NOX2), in the development of cardiac dysfunction in obesity/diabetes. We also wanted to examine the potential link between ... -
Risk Factors and Triggers of Venous Thromboembolism in Patients with Myocardial Infarction
(Doctoral thesis; Doktorgradsavhandling, 2022-06-17)<p>During the past decades, extensive data from the general population have revealed that patients with acute myocardial infarction (MI) are at increased risk of venous thromboembolism (VTE, i.e., deep vein thrombosis [DVT] and pulmonary embolism [PE]). The risk is highest in the initial 0-6 months following an acute MI, and declines rapidly thereafter. The explanation for the observed association ... -
Geographic and socioeconomic variation in the utilisation of specialist health care services in Norway – Three selected health care services
(Doctoral thesis; Doktorgradsavhandling, 2022-06-21)<p>The overall theme of this thesis is geographic and socioeconomic variation in the use of specialist health care services. Three different health care services were studied. Complete population data on individual level with high level of quality from nationwide registries (i.e., The Norwegian Patient Registry, The Cancer Registry of Norway and Statistics Norway) were used in the analysis. <p>The ... -
Prediction of outcome in patients with severe aortic stenosis treated with transcatheter aortic valve implantation
(Doctoral thesis; Doktorgradsavhandling, 2022-06-17)Surgical aortic valve replacement (SAVR) has until the last decade been the standard treatment for patients with aortic stenosis (AS). However, many patients were not offered surgical treatment due to high age or unacceptable surgical risk estimated by surgical risk scores. Transcatheter aortic valve implantation (TAVI) is a less invasive treatment modality where the valve is implanted using a ... -
Microscopy Meets Nanomedicine: The Challenge of Liposomes. Selecting, Understanding, and Adapting Imaging Techniques to Localize and Characterize Nanocarriers
(Doctoral thesis; Doktorgradsavhandling, 2022-06-10)Nanocarriers have brought several medical advances through better diagnostics and improved drug therapy. Yet, many promising preclinical findings were never translated into clinical success, consequently slowing drug development, and increasing its financial burden. By reliably predicting the nanoparticle fate at in vitro stages, the disappointment of suboptimal in vivo outcome could be avoided. To ... -
Vitamin D: Relations with Sleep and Bone Mineral Density. Insights from the Tromsø Study and randomized controlled trials
(Doctoral thesis; Doktorgradsavhandling, 2022-06-10)In this thesis, the relationship between vitamin D and health-related outcomes has been investigated. More than 21,000 individuals participated in the Tromsø Study 2015-16. The participants donated blood samples and filled in questionnaires regarding their health status, including questions about their sleep health. Using these data, the association between vitamin D and sleep duration, daytime ...


English
norsk